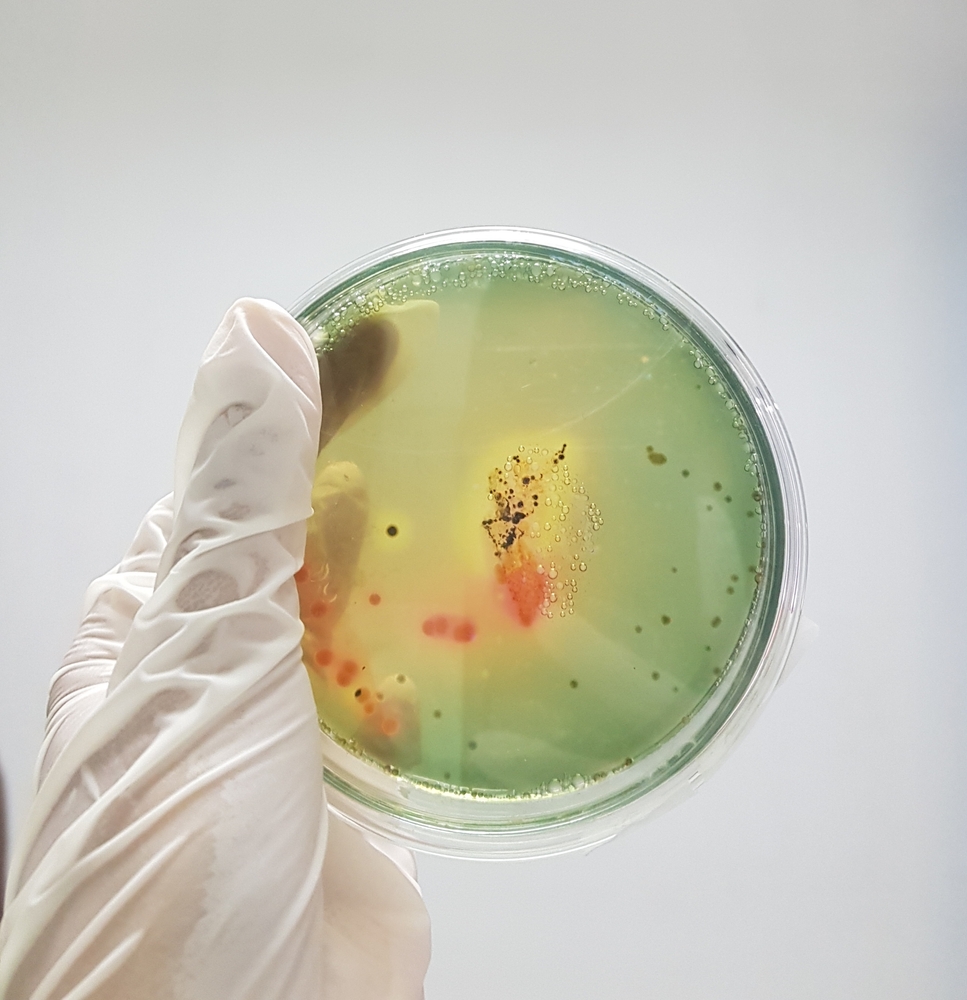
You are currently viewing Mt. Healthy Hatcheries In Ohio Linked To Salmonella Outbreak

Ohio Hatcheries Linked To Salmonella Outbreak And Possible Infection Of Salmonella Infantis Or Salmonella Newport
The federal Centers for Disease Control and Prevention (CDC) has announced the recall of a variety of live chicks and ducks sold through mail-order hatchery Mt. Healthy Hatcheries in Ohio due to the possible infection of Salmonella Infantis or Salmonella Newport. According to data from the CDC, 60 persons who purchased the chicks from the Ohio hatchery were infected with the bacteria in 23 different states.
The CDC announced that the chicks and ducks are being recalled by the Mt. Healthy Hatcheries in Ohio after 81 percent of the people infected with salmonella reported touching live poultry the week before they started showing symptoms. 31 percent of these individuals were hospitalized, but no deaths have been reported from the illness. The CDC traced the infection to Mt. Healthy Hatcheries in Ohio, which has been responsible for outbreaks of salmonella through live poultry in 2012 and 2013 as well. As of May 8th, 60 cases were reported, with 6 of the cases in Ohio. The two other states with the most infections were New York, with 6, and Pennsylvania, with 8. Other states reported 4 or fewer infections. Most cases reported feeling ill between February 4th 2014 and April 21st 2014. 40 percent of cases were in children younger than 10. 57 percent of the infections were in males.
The CDC is working with the U.S. Department of Agriculture’s Animal and Plant Health Inspection Service (USDA-APHIS) to further investigate the outbreak of salmonella across the country. The PulseNet system is being used to identify the outbreaks. This network looks for DNA bacterial “fingerprints” in a lab that show the bacteria in diagnostic testing using pulsed-field gel electrophoresis (PFGE). The CDC used a chart called an epidemic curve to track the number of outbreaks visually. It can take up to 4 weeks for an illness to be reported to the CDC, which indicates that more persons may be affected by the salmonella outbreak if connected to live poultry from Mt. Healthy Hatcheries. [May 2014, http://www.cincinnati.com/story/news/your-watchdog/2014/05/09/advisories-and-recalls/8916107/]
The USDA-APHIS and the CDC interviewed ill persons about their contact with animals and foods in the week before they became ill. 90 percent of individuals who had available purchase information on their live poultry indicated that they purchased their poultry from 5 different store companies in multiple states. However, all of these stores sold poultry raised by Mt. Healthy Hatcheries in Ohio. The hatchery uses several source flocks for eggs and chicks, so the exact origin of the salmonella outbreak is unknown. The USDA-APHIS and the CDC have worked with Mt. Healthy Hatcheries after the outbreaks in 2012 and 2013 to reduce the chances of another salmonella outbreak, but further efforts will be taken. The company is already participating in the USDA National Poultry Improvement Plan, designed to eliminate the most common strains of Salmonella that contribute to illness.
The CDC recommends that individuals who purchase live poultry take care to avoid spreading the bacteria by washing hands with soap and water after touching the birds, and by keeping any surface the bird touches clean by disinfecting it regularly. The CDC also recommends keeping poultry outside the home and states that all agricultural stores selling live poultry provide safety and health information about the risk of live poultry to customers. [May 2014, http://www.cdc.go